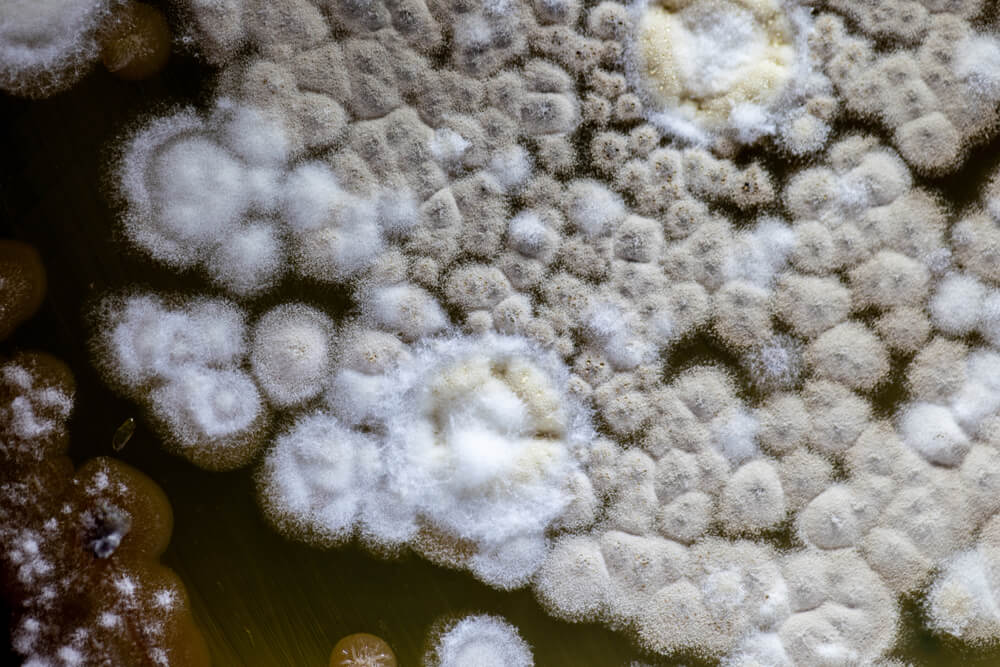

Küf Nasıl Önlenir?
Küf Nasıl Önlenir?
Evinizdeki küfü gidermek için, daima küfün gelişmek için ihtiyaç duyacağı koşulların oluşmamasını sağlamanız gerekir. Küf birçok bölgede özellikle de havasız, nemli ve karanlık yerlerde oluşur. Bu faktörler için önlem alarak, evinizde küf oluşumunu asgari düzeye indirmiş olursunuz.
Küf Oluşumunu Önlemeye Yönelik Bazı Püf Noktaları:
- Havalandırın: Söz konusu alanları en az ay da bir havalandırarak hava sirkülasyonunun olmasını sağlayın.
- Havanın kuru olmasını sağlayın: Nem, küf oluşumunda büyük rol oynar. Küfün önünü almak için, evinizin içindeki nemi tercihen % 45-55 arasında tutarak ve % 65’in üstüne çıkmasına izin vermeyerek kontrol etmek suretiyle, sporların çimlenmesi için gerekli nemi ortadan kaldırın. Bazı noktalara nem gidericiler de koyabilirsiniz.
- Temiz tutun: Yerde ve göz önünde olmayan noktalarda (mahzenler, kilerler) küçük bile olsa yiyecek kırıntıları olmaması gerekir. Küf sadece orada oluşmakla kalmayacak, aynı zamanda çevreye de bulaşacaktır.
- Buzdolabınıza bakın: Küf oluşumunu engellemek için daima yiyeceklerinizi kapalı tutmaya çalışın ve buzdolabınıza son kullanım tarihini geçmiş ürünler koymayın.
- Malzemeleri depolarken, saklama yapılan eşyayı kapatmadan önce neme karşı koruma sağlamak için nem gidericiler kullanmak aşırı nemi engellemenize yardımcı olacaktır.
- Banyo zeminleri söz konusu olduğunda her duştan sonra ve ara sıra banyoyu duş perdesi de açık olarak havalandırın.
- Bodrum katlarında, özellikle dış duvarlara bakın. Eğer bodrum nemliyse, zeminlerin altına ve duvarların arkasına bakın. Bodrumda küf oluşumu ve küf kokusu sözkonusuysa zeminin üzerine klorlu kireç serpin, birkaç gün sonra süpürerek temizleyin. Bodrumdaki hava dolaşımının artırılması da bu işleme yardımcı olacaktır.
Bütün önlemlere rağmen küf oluşursa yalnız temizlik yaparak tekrar küf oluşumunun önüne geçemeyebilirsiniz. Bunun yerine, bahçenizdeki yabani otlar gibi küfü de kökten kazımanız gerekir. Kaliteli bir küf öldürücü dezenfektan, bu aşamada işinize yarayabilir.